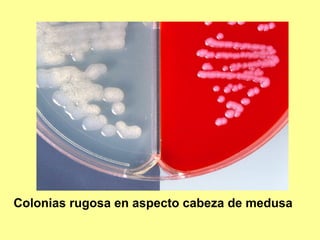
Colonias rugosa en aspecto cabeza de medusa

Este documento clasifica y describe varios géneros de bacilos gram positivos. Describe las características de Bacillus anthracis, Bacillus cereus, y tres especies de Clostridium (C. tetani, C. botulinum, C. perfringens). Explica sus hábitats, mecanismos de transmisión, factores de virulencia, enfermedades que causan y métodos de identificación.